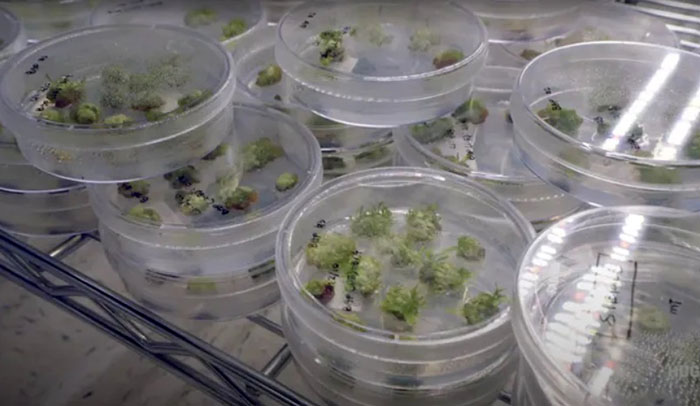

Вони повинні боротися з вуглецевими викидами.
У середині лютого на узліссі в американському штаті Джорджія компанія Living Carbon висадила п'ять тисяч саджанців генетично модифікованих тополь. За словами репортерів та екологів, це безпрецедентний випадок, коли приватна компанія отримала дозвіл на вирощування ГМ-рослин у рекордні терміни, причому навіть не маючи наукових публікацій, здатних підтвердити, що дерева справді можуть вирішити завдання, для якого вони були розроблені.
За твердженням творців, новий сорт тополь має більш ефективний фотосинтез, що в теорії дозволяє таким деревам рости в півтора рази швидше за диких родичів. Засновники компанії, які мають намір протягом року висадити кілька мільйонів подібних саджанців, заявляють, що таким чином мають намір боротися із підвищенням концентрації CO₂ в атмосфері, а отже, і зі зміною клімату.
Генно-модифіковані пагони тополь у лабораторії Living Carbon
Перед тим як «випустити» дерева в природне довкілля, їх випробували лише в теплиці, де й були отримані обнадійливі результати за швидкістю їх зростання. Але жодних польових випробувань перед масштабною висадкою не було проведено. Проте представникам компанії Living Carbon якимось чином вдалося отримати дозвіл на висадку дерев у максимально короткі терміни, що шокувало не лише представників екологічної організації The Global Justice Ecology Project, які борються з висадженням ГМ-дерев, а й найближчих конкурентів Living Carbon — група вчених, які вже третій рік чекають на дозвіл на широкомасштабне вирощування американського каштану, стійкого до грибка.
Як пише The New York Times, засновники Living Carbon використовували лазівку у законодавстві, яка дозволяє уникнути регулювання з боку федеральної влади (USDA). Справа в тому, що для генетичної модифікації своїх рослин вони застосували досить примітивний метод, який формально, з юридичної точки зору, не робив їх рослини «модифікованими».
Йдеться про використання «генної гармати» — способу доставки ДНК, що передбачає буквально обстріл клітин рослини мікроскопічними кульками золота, покритими генетичним матеріалом. Цей метод теж добре відомий і досить надійний, але його важливий недолік полягає в тому, що потрібні гени в результаті обстрілу можуть вбудуватися в довільне місце геному. І формально, і з погляду фізіології отримані таким чином рослини — це зовсім не те саме, що саджанці, які були отримані за допомогою агробактерій і для яких у препринті було показано приріст біомаси 50% порівняно з вихідними тополями.

Засновники Living Carbon Медді Холл та Патрік Меллор у розпліднику
Засновники Living Carbon визнають деякі екологічні ризики, тому на пілотній плантації в Джорджії ГМ-тополі ростуть упереміж із звичайними — заразом це дозволяє поставити науковий експеримент, за допомогою якого дійсно можна буде оцінити, чи мають ГМ-дерева заявлені властивості. Всі ГМ-дерева є жіночими, тобто не виробляють пилку. Крім тополь на ділянці висадять інші види, щоб оцінити вплив ГМ-дерев на біорізноманіття.
За матеріалами видання "Медуза"
